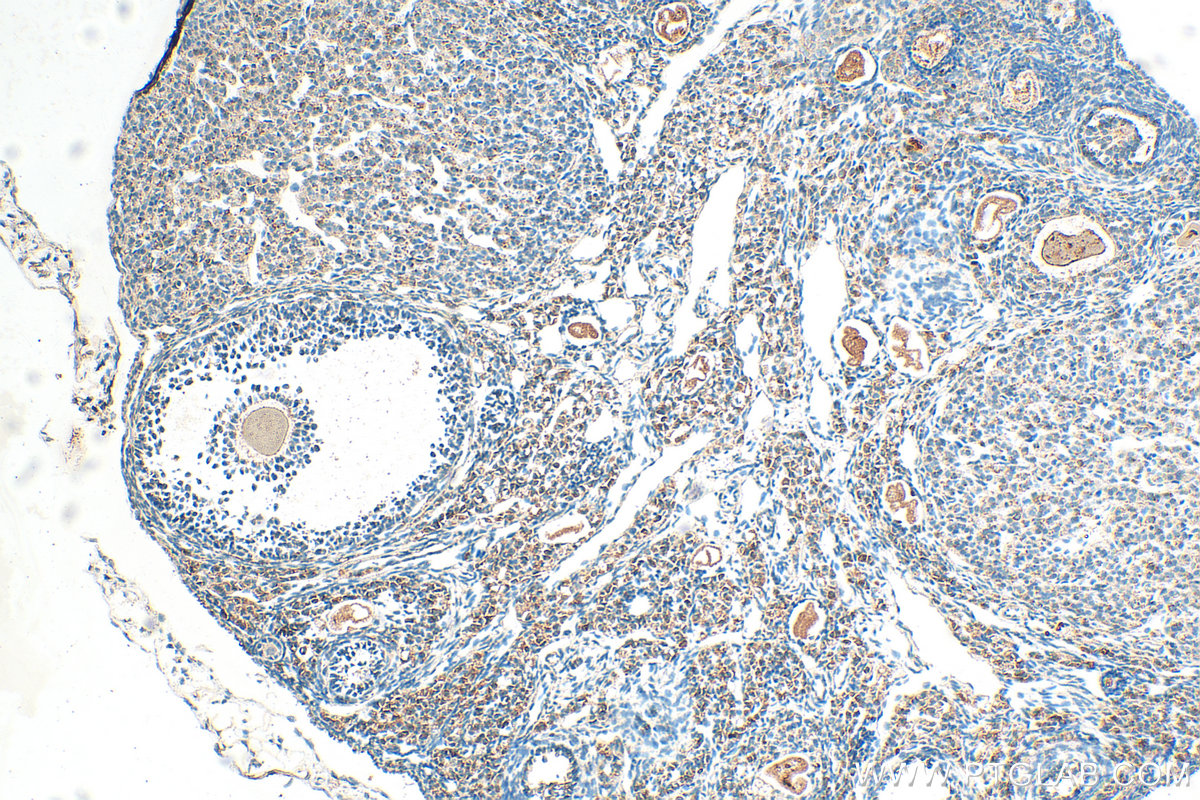

验证数据展示
经过测试的应用
| Positive WB detected in | HeLa cells, HCT 116 cells, HepG2 cells, MCF-7 cells, MDA-MB-231 cells |
| Positive IHC detected in | mouse ovary tissue, human skin tissue, human testis tissue Note: suggested antigen retrieval with TE buffer pH 9.0; (*) Alternatively, antigen retrieval may be performed with citrate buffer pH 6.0 |
推荐稀释比
| 应用 | 推荐稀释比 |
|---|---|
| Western Blot (WB) | WB : 1:5000-1:15000 |
| Immunohistochemistry (IHC) | IHC : 1:50-1:500 |
| It is recommended that this reagent should be titrated in each testing system to obtain optimal results. | |
| Sample-dependent, Check data in validation data gallery. | |
产品信息
13546-1-AP targets ST3GAL4 in WB, IHC, IF, ELISA applications and shows reactivity with human, mouse samples.
| 经测试应用 | WB, IHC, ELISA Application Description |
| 文献引用应用 | WB, IHC, IF |
| 经测试反应性 | human, mouse |
| 文献引用反应性 | human, mouse |
| 免疫原 |
CatNo: Ag3665 Product name: Recombinant human ST3GAL4 protein Source: e coli.-derived, PGEX-4T Tag: GST Domain: 1-333 aa of BC010645 Sequence: MVSKSRWKLLAMLALVLVVMVWYSISREDRYIELFYFPIPEKKEPCLQGEAESKASKLFGNYSRDQPIFLRLEDYFWVKTPSAYELPYGTKGSEDLLLRVLAITSSSIPKNIQSLRCRRCVVVGNGHRLRNSSLGDAINKYDVVIRLNNAPVAGYEGDVGSKTTMRLFYPESAHFDPKVENNPDTLLVLVAFKAMDFHWIETILSDKKRVRKGFWKQPPLIWDVNPKQIRILNPFFMEIAADKLLSLPMQQPRKIKQKPTTGLLAITLALHLCDLVHIAGFGYPDAYNKKQTIHYYEQITLKSMAGSGHNVSQEALAIKRMLEMGAIKNLTSF 种属同源性预测 |
| 宿主/亚型 | Rabbit / IgG |
| 抗体类别 | Polyclonal |
| 产品类型 | Antibody |
| 全称 | ST3 beta-galactoside alpha-2,3-sialyltransferase 4 |
| 别名 | Alpha 2,3-sialyltransferase IV, Alpha 2,3-ST 4, Beta-galactoside alpha-2,3-sialyltransferase 4, CGS23, CMP-N-acetylneuraminate-beta-galactosamide-alpha-2,3-sialyltransferase 4 |
| 计算分子量 | 333 aa, 38 kDa |
| 观测分子量 | 36 kDa |
| GenBank蛋白编号 | BC010645 |
| 基因名称 | ST3GAL4 |
| Gene ID (NCBI) | 6484 |
| RRID | AB_10597402 |
| 偶联类型 | Unconjugated |
| 形式 | Liquid |
| 纯化方式 | Antigen affinity purification |
| UNIPROT ID | Q11206 |
| 储存缓冲液 | PBS with 0.02% sodium azide and 50% glycerol, pH 7.3. |
| 储存条件 | Store at -20°C. Stable for one year after shipment. Aliquoting is unnecessary for -20oC storage. |
背景介绍
ST3GAL4, also known as CGS23, NANTA3 and SIAT4C, is a member of the glycosyltransferase 29 family. ST3GAL4 protein exists in multiple splice variants and is frequently modified by glycosylation. ST3GAL4 is expressed uniformly in tissues and organs during all stages of development, and the subcellular localization is currently not clear.
实验方案
| Product Specific Protocols | |
|---|---|
| IHC protocol for ST3GAL4 antibody 13546-1-AP | Download protocol |
| WB protocol for ST3GAL4 antibody 13546-1-AP | Download protocol |
| Standard Protocols | |
|---|---|
| Click here to view our Standard Protocols |
发表文章
| Species | Application | Title |
|---|---|---|
Front Oncol ST3Gal IV Mediates the Growth and Proliferation of Cervical Cancer Cells In Vitro and In Vivo Via the Notch/p21/CDKs Pathway. | ||
Sci Rep Five hypoxia and immunity related genes as potential biomarkers for the prognosis of osteosarcoma. | ||
FEBS Lett The sialyltransferase ST3Gal3 facilitates the receptivity of the uterine endometrium in vitro and in vivo. | ||
Glycobiology Sialylation-dependent interaction between PD-L1 and CD169 promotes monocytes adhesion to endothelial cells | ||
Elife RANK+TLR2+ myeloid subpopulation converts autoimmune to joint destruction in rheumatoid arthritis | ||